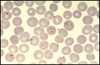

MIR Flashcards
PLASTIC SURGERY (473 cards)
la leptospira es aerobia o anaerobia?
AEROBIA, porque respira
Chediak.Higashi
enf con déficit de formación lisosomal
- albinismo parcial
- hipopigmentación iris
- alt hemostasia primaria
- defecto fagocitosis
tto Enterococcus faecalis
Ampicilina + AG (genta)
sinergia atb
es resistente a cefalosporinas, incluso las de última generación
2 microorganismos que son resistentes a cefalosporinas y solo sensibles a ampicilina
- enterococo (St faecAMlis)
-
listeria monocytogenes
- ampi o penicilina
los infiltrados de la tbc miliar se localizan en
bases
complejo de Ghon
forma de primoinfección
lesión pulmonar TBC + linfangitis + gg hiliares calcificados
como son las heces en el colera
heces en agua de arroz
NO productos patologicos
gangrena sinérgica bacteriana progresiva
de Meleney
torax/abdomen
diabeticos
tto nocardia
sulfisoxazol
que etiología sospecha en la aparicion de una hepatitis en el contexto de una neumonía atípica
Coxiella burnetti
causa mas frec de crisis convulsiva en VIH
encedalopatía VIH > toxoplasma
linfoma cerebral primario se asocia a
infección por VEB
ppal mecanismo de resistencia a las quinolonas
mutaciones en la DNA girasa y topoisomerasa IV
la micobateria causante de la tbc es cromógena?
NO
Dx definitivo cryptococosis
detección Ag capsular criptococo mediante aglutinación en latex del LCR (tb puede hacerse en suepro)
bacilos gram + en LCR de paciente inmunodeprimido
listeria monocytogenes
que está totalmente contraindicado en abcesos cerebrales
punción lumbar
tto brucelosis
- estreptomicina i.m. 2 sem + doxicilina v.o. 6 sem
- ****alternativa
- RIfampicina + doxiciclina
pauta tto TBC en vih+
igual que en resto
- solo si CD4< 100—-> RIPE 9
tto paludismo de especies sensibles
- cloroquina
- cloroquina + primaquina—> P vivax y ovale
la mosca negra es el vector de la transmisión de….
filaria Onchocerca volvulus
“Ceguera de los ríos”
quw hongo NO tiene ergosterol en su Mb citoplasmática
P jirovecci
hongo unicelular
medio cultivo especifico para Salmonella
Wilson Blair